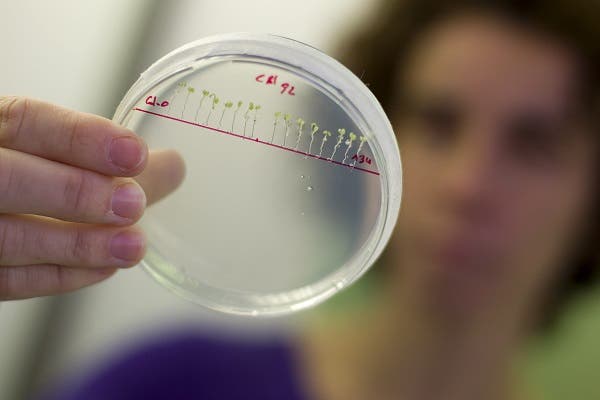
salud de la mujer

Y aunque hormonas y genes estén muy presentes en la salud de la mujer, los estilos de vida y los condicionantes sociales, económicos y culturales también dejan su huella. Ignorar todo el conjunto lleva a tratamientos médicos inadecuados, exploraciones ineficaces y errores de diagnóstico.
“Las mujeres y los hombres somos distintos a la hora de comportarnos ante la salud. Sin embargo, la salud de la mujer ha estado mediatizada por un enfoque androcéntrico”, que es necesario corregir, defiende en una entrevista a EFEsalud, Antón Herreros, presidente de la Fundación para la Investigación de la Salud (FUINSA).
FUINSA ha puesto en marcha el Foro Salud de la Mujer para avanzar en el conocimiento sobre morbilidades específicas de las mujeres, y qué factores las determinan, “ya que sólo una visión de los problemas de salud basados conjuntamente en los aspectos biológicos, psicológicos y sociales, nos podrán aportar un modelo válido para estudiar las desigualdades de género en la salud”, explica este médico.
Ensayos clínicos
Son desigualdades que se plasman también en la ausencia de las mujeres en numerosos ensayos clínicos con medicamentos.
Hasta hace bien poco, las mujeres han sido sistemáticamente excluidas de los ensayos clínicos, de manera que muchos se han llevado a cabo solo con población masculina, lo que ha conducido a que numerosos fármacos no sean igual de eficaces para las mujeres o, lo que es peor, que tengan efectos adversos para las mismas, explica a EFEsalud Rosario López Giménez, profesora de la facultad de Medicina de la Universidad Autónoma de Madrid y experta en salud y género.

De hecho, y según Rosario López, muchos de los medicamentos retirados del mercado, lo han sido tras comprobarse los efectos adversos que provocaban en la salud de las mujeres.
Otra cuestión, refiere esta experta, es la de las dosis. Las mujeres no metabolizan igual que los hombres, y las dosis indicadas de manera general pueden servir para los hombres, pero no ser las correctas para las mujeres.
La cuestión no está ni mucho menos resuelta hoy en día, tanto que ha merecido que el pleno de la Eurocámara haya pedido hace apenas unos días que los ensayos clínicos tengan en cuenta la cuestión de género y distingan entre los efectos secundarios que los medicamentos pueden causar a hombres y mujeres, con mayor incidencia de enfermedades mentales como la depresión.
En el informe, del que fue ponente la eurodiputada española independiente liberal Beatriz Becerra, se afirma que actualmente las mujeres están poco representadas en la investigación clínica, aunque se les suministran los mismos medicamentos, incluso ante enfermedades donde las diferencias pueden ser tan perjudiciales como el alzhéimer, el cáncer, el tratamiento de los ictus, los antidepresivos y las enfermedades cardiovasculares.
Los estudios confirman ya las claras diferencias entre ambos géneros, aunque se trate de la misma enfermedad. Algunos ejemplos son la osteoporosis, las enfermedades autoinmunes, hepáticas y tiroideas; la fibromialgia, los trastornos de alimentación, el síndrome de intestino irritable o la depresión y ansiedad.
En esta batalla por no olvidarse del género cuando un facultativo atiende a un paciente es fundamental, apunta el presidente de FUINSA, la transferencia de unos conocimientos que están ahí pero no se publicitan o comparten lo suficiente.
Salud Mujer: lo que dice la OMS
En un informe de 2009, la Organización Mundial de la Salud (OMS) ya advertía que el hecho de pertenecer a uno u otro sexo tenía un gran impacto en la salud.
En su introducción señalaba que, aún cuando se han realizado algunos progresos, las sociedades del mundo entero “siguen fallando a la mujer en momentos clave de su vida, particularmente en la adolescencia y la vejez”.
También refería que aunque el grueso de la atención sanitaria está a cargo de mujeres, éstas pocas veces reciben la atención que ellas mismas necesitan.



Debe estar conectado para enviar un comentario.